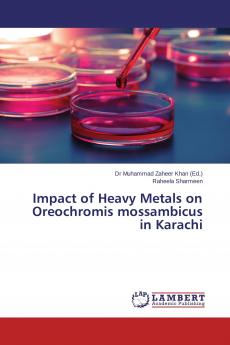
Impact of Heavy Metals on Oreochromis mossambicus in Karachi

Paperback
₹7560
(All inclusive*)
Delivery Options
Please enter pincode to check delivery time.
*COD & Shipping Charges may apply on certain items.
Review final details at checkout.
Looking to place a bulk order? SUBMIT DETAILS
About The Book
Description
Author
In this study Heavy metals (Cd Cr Cu and Pb) concentrations were determined in surface and deep water samples along with their accumulation in tissues of the fish Oreochromis mossambicus from Malir River Karachi Pakistan. This study revealed that the concentrations of selected heavy metals cadmium chromium copper and lead in water samples were found higher than the values recommended in drinking water by FAO/WHO (1993) NEQS (1993) WHO (1996) and JECFA (2000). But fortunately the water of Malir River is not used for drinking purposes. The research techniques and information are helpful for graduate and research students of Biological and Environmental Sciences NGOs Research Organizations etc.
Delivery Options
Please enter pincode to check delivery time.
*COD & Shipping Charges may apply on certain items.
Review final details at checkout.
Details
ISBN 13
9783659769924
Publication Date
-24-08-2015
Pages
-200
Weight
-278 grams
Dimensions
-150x220x10.88 mm